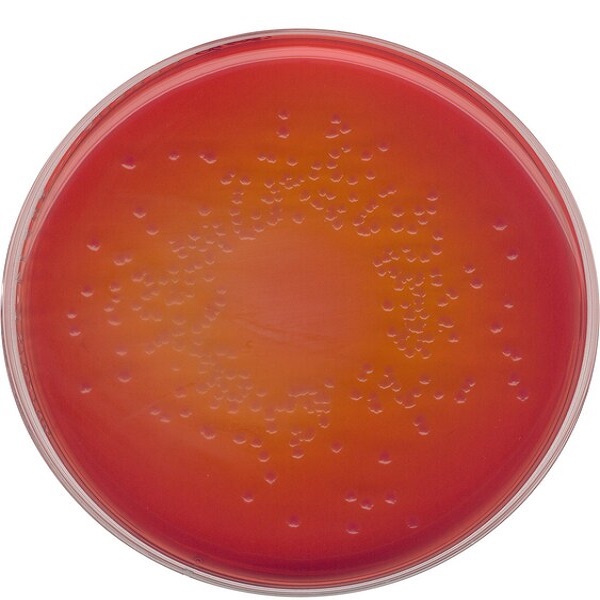

محیط کشت راپاپورت واسیلیادیس براث RVS کد 107700 مرک
0
0
RVS (RAPPAPORT-VASSILIADIS-Soya)
محیط کشت
.
محیط کشت مرک
.
مرک
.
مواد زیستی
.
مواد شیمیایی آزمایشگاهی